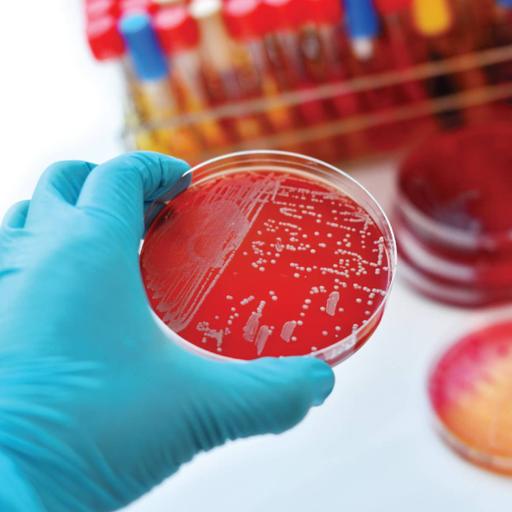
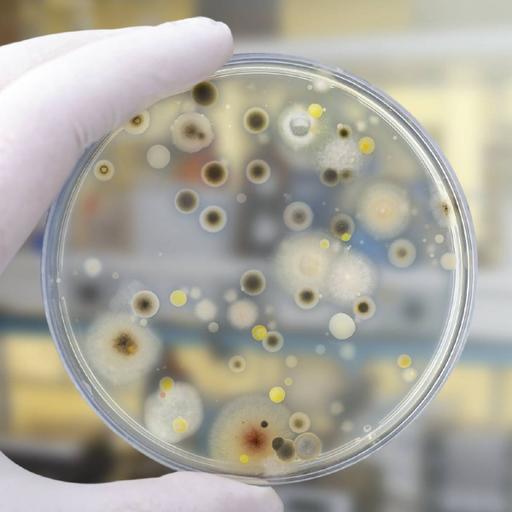
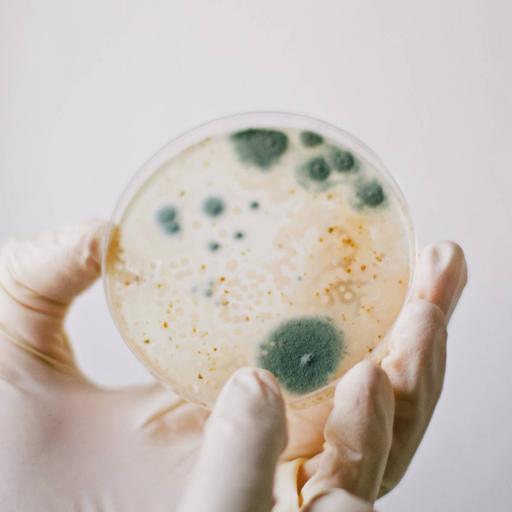
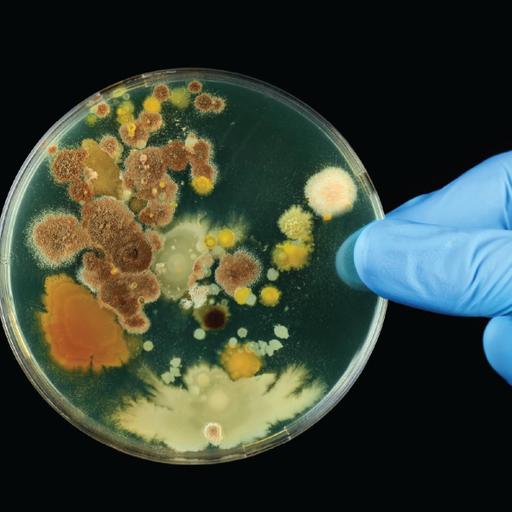

A post graduate student with strong analytical skills and ability to multitask. Reshma is self-motivated and adaptable to dynamic working conditions. She is equally diligent and passionate willing to innovate new things which can improve existing technologies.
View more